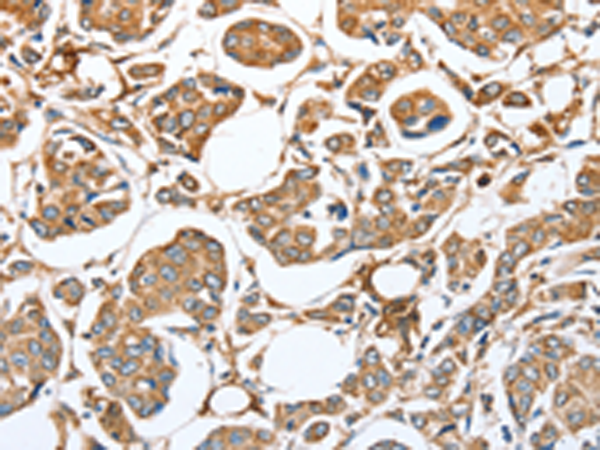

中文名稱(chēng):兔抗CAPG多克隆抗體
英文名稱(chēng): Anti-CAPG rabbit polyclonal antibody
別 名: MCP; AFCP
儲(chǔ) 存: 冷凍(-20℃)
相關(guān)類(lèi)別: 一抗
反應(yīng)種屬: Human, Mouse, Rat
標(biāo) 記 物: Unconjugate
克隆類(lèi)型: rabbit polyclonal
技術(shù)規(guī)格
|
Background: |
This gene encodes a member of the gelsolin/villin family of actin-regulatory proteins. The encoded protein reversibly blocks the barbed ends of F-actin filaments in a Ca2+ and phosphoinositide-regulated manner, but does not sever preformed actin filaments. By capping the barbed ends of actin filaments, the encoded protein contributes to the control of actin-based motility in non-muscle cells. Alternatively spliced transcript variants have been observed for this gene. |
|
Applications: |
ELISA, WB, IHC |
|
Name of antibody: |
CAPG |
|
Immunogen: |
Fusion protein of human CAPG |
|
Full name: |
Capping protein (actin filament), gelsolin-like |
|
Synonyms: |
MCP; AFCP |
|
SwissProt: |
P40121 |
|
ELISA Recommended dilution: |
2000-5000 |
|
IHC positive control: |
Human breast cancer and Human colon cancer |
|
IHC Recommend dilution: |
50-200 |
|
WB Predicted band size: |
38 kDa |
|
WB Positive control: |
Mouse lung and human fetal lung tissue, hela cells |
|
WB Recommended dilution: |
500-2000 |

購(gòu)物車(chē)
幫助
021-54845833/15800441009
